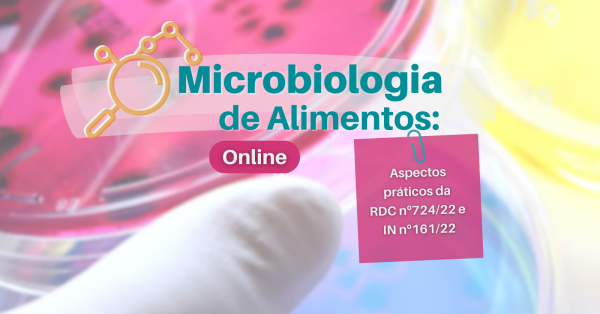
Imagem do evento Microbiologia de Alimentos

Conteúdos para profissionais da saúde
657 eventos encontrados
Página 1 de 42

Telereabilitação na prática para Fisioterapeutas
Por Samuel Wesley Rocha

Resumo de clínica cirúrgica de grandes animais
Por ANA PAULA ANDREOTTI TOLEDO

Curso de Pressão Arterial e Fisioterapia
Por Samuel Wesley Rocha

Contracepção na Prática Vale o Investimento? É Bom SIM OU NÃO?
Por PAULA KAREN

Pós Graduação em Fisioterapia Cardiorrespiratória Adulto, Pediátrica e Neonatal
Por Fisioterapia Campos

E-book Grátis: E-book Grátis: Guia para a Interpretação da ISO 56001:2024
Por Adryse Marques

A interpretação dos sonhos
Por Carolina Borges de Andrade

Entrevistas Preliminares - táticas e estratégias
Por Psicanalista Fabiana Ratti - Unbewusste

Resumo de Clínica Médica de Pequenos Animais
Por ANA PAULA ANDREOTTI TOLEDO
Microbiologia de Alimentos
Por Baktron Cursos

Formei e Agora?
Por Projeto - Clínica Sócio-Histórica

Boas Práticas de Manipulação de Quimioterápicos
Por Liziane França

Seminário 5 - Mod. 2 - Os Três tempos do Édipo e Metáfora Paterna
Por Psicanalista Fabiana Ratti - Unbewusste

Curso Interpretação de Exames de Imagem
Por Fisioterapia Campos

Extensão Universitária em Plantas Medicinais, Fitoterapia e Práticas Integrativas
Por Agnes' Natuterapias

Bioinformática Descomplicada - Análise Genômica
Por Natália Quintanilha